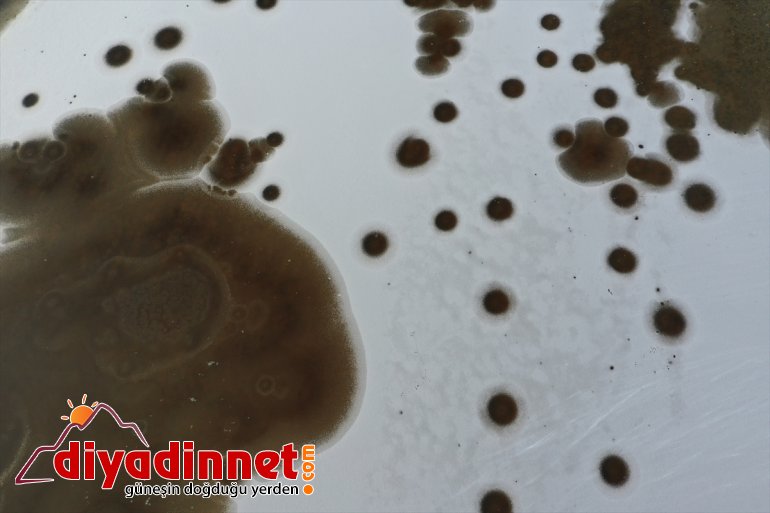
Milli sulak buzla - kaplandı alanlar (DRONE) Dağı IĞDIR Ağrı Parkı
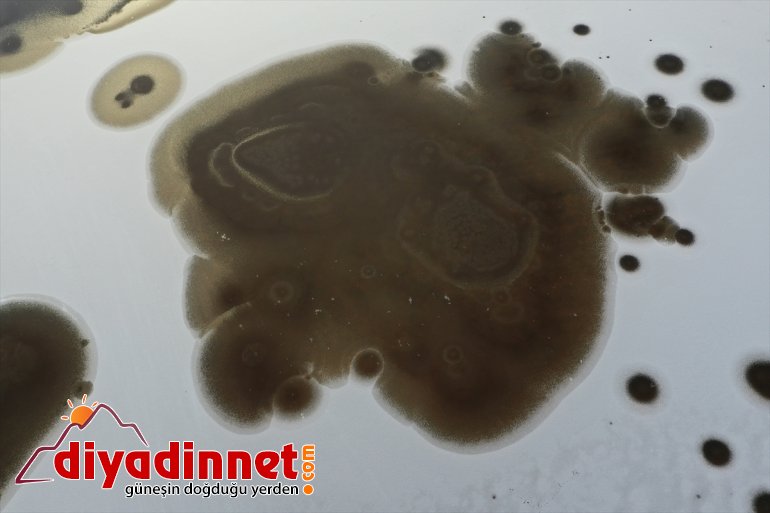
Parkı
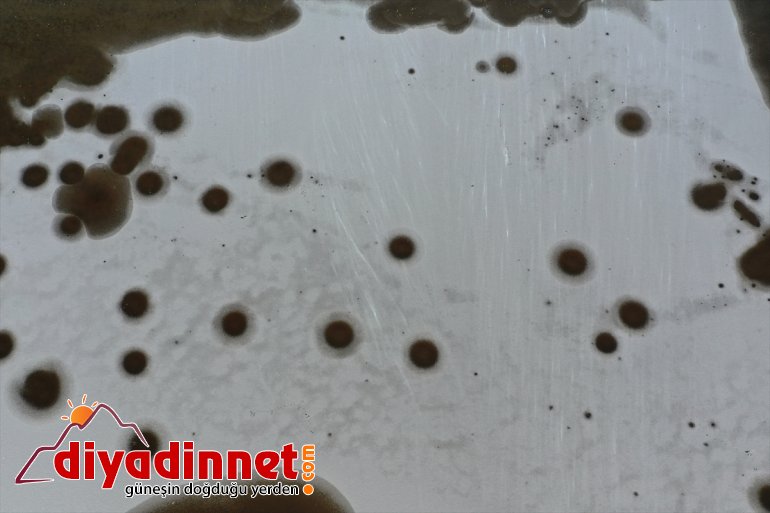
kaplandı Parkı

Iğdır - Iğdır'da etkili olan soğuk havadan dolayı bazı sulak alanların yüzeyi buz tuttu.
Hava sıcaklığının sıfırın altında 8 dereceye kadar düştüğü ilde dereler dondu.
Türkiye'nin en büyük milli parkı olan Ağrı Dağı Milli Parkı'ndaki sulak alanlar da buzla kaplandı.
Henüz kar yağışının olmadığı, fakat hava sıcaklığının düşmesi nedeniyle donan bölgedeki su kaynakları, drone ile havadan görüntülendi.

Kaynak: ANADOLU AJANSI
Diyadinnet.com olarak, Iğdır haberinin içeriğini herhangi bir şekilde değiştirmeden, abonesi olduğumuz Anadolu Ajansı ve İhlas Haber Ajansı (İHA)'dan aldığımız haliyle sizlere sunuyoruz. Iğdır Haberleri kategorisindeki bu haberin doğruluğu ve güvenilirliği ile ilgili tüm hukuki sorumluluk ilgili haber ajanslarına aittir..
- Diyadinnet.com olarak, sizlere en güncel ve doğru haberleri sunmayı ilke ediniyoruz. Bu kapsamda, Iğdır'ın dört bir yanından Güncel haberleri de dahil olmak üzere, Ağrı Dağı, Drone, Iğdır, Kar Yağışı, Türkiye gibi önemli konularda haberleri takip ediyor ve sizlerle paylaşıyoruz.
- Diyadinnet.com'u daha da geliştirmek için sizden gelen geri bildirimler bizim için çok önemlidir. Haberlerimizin içeriğiyle ilgili herhangi bir endişe, öneri veya sorunuz olursa lütfen bizimle iletişime geçmekten çekinmeyin.
- Haberle ilgili yorumlarınızı ve düşüncelerinizi aşağıdaki yorum bölümünde paylaşabilirsiniz.
- Bu haberi beğendiyseniz, lütfen sosyal medya hesaplarınızda paylaşarak sevdiklerinizin de haberdar olmasını sağlayabilirsiniz.






